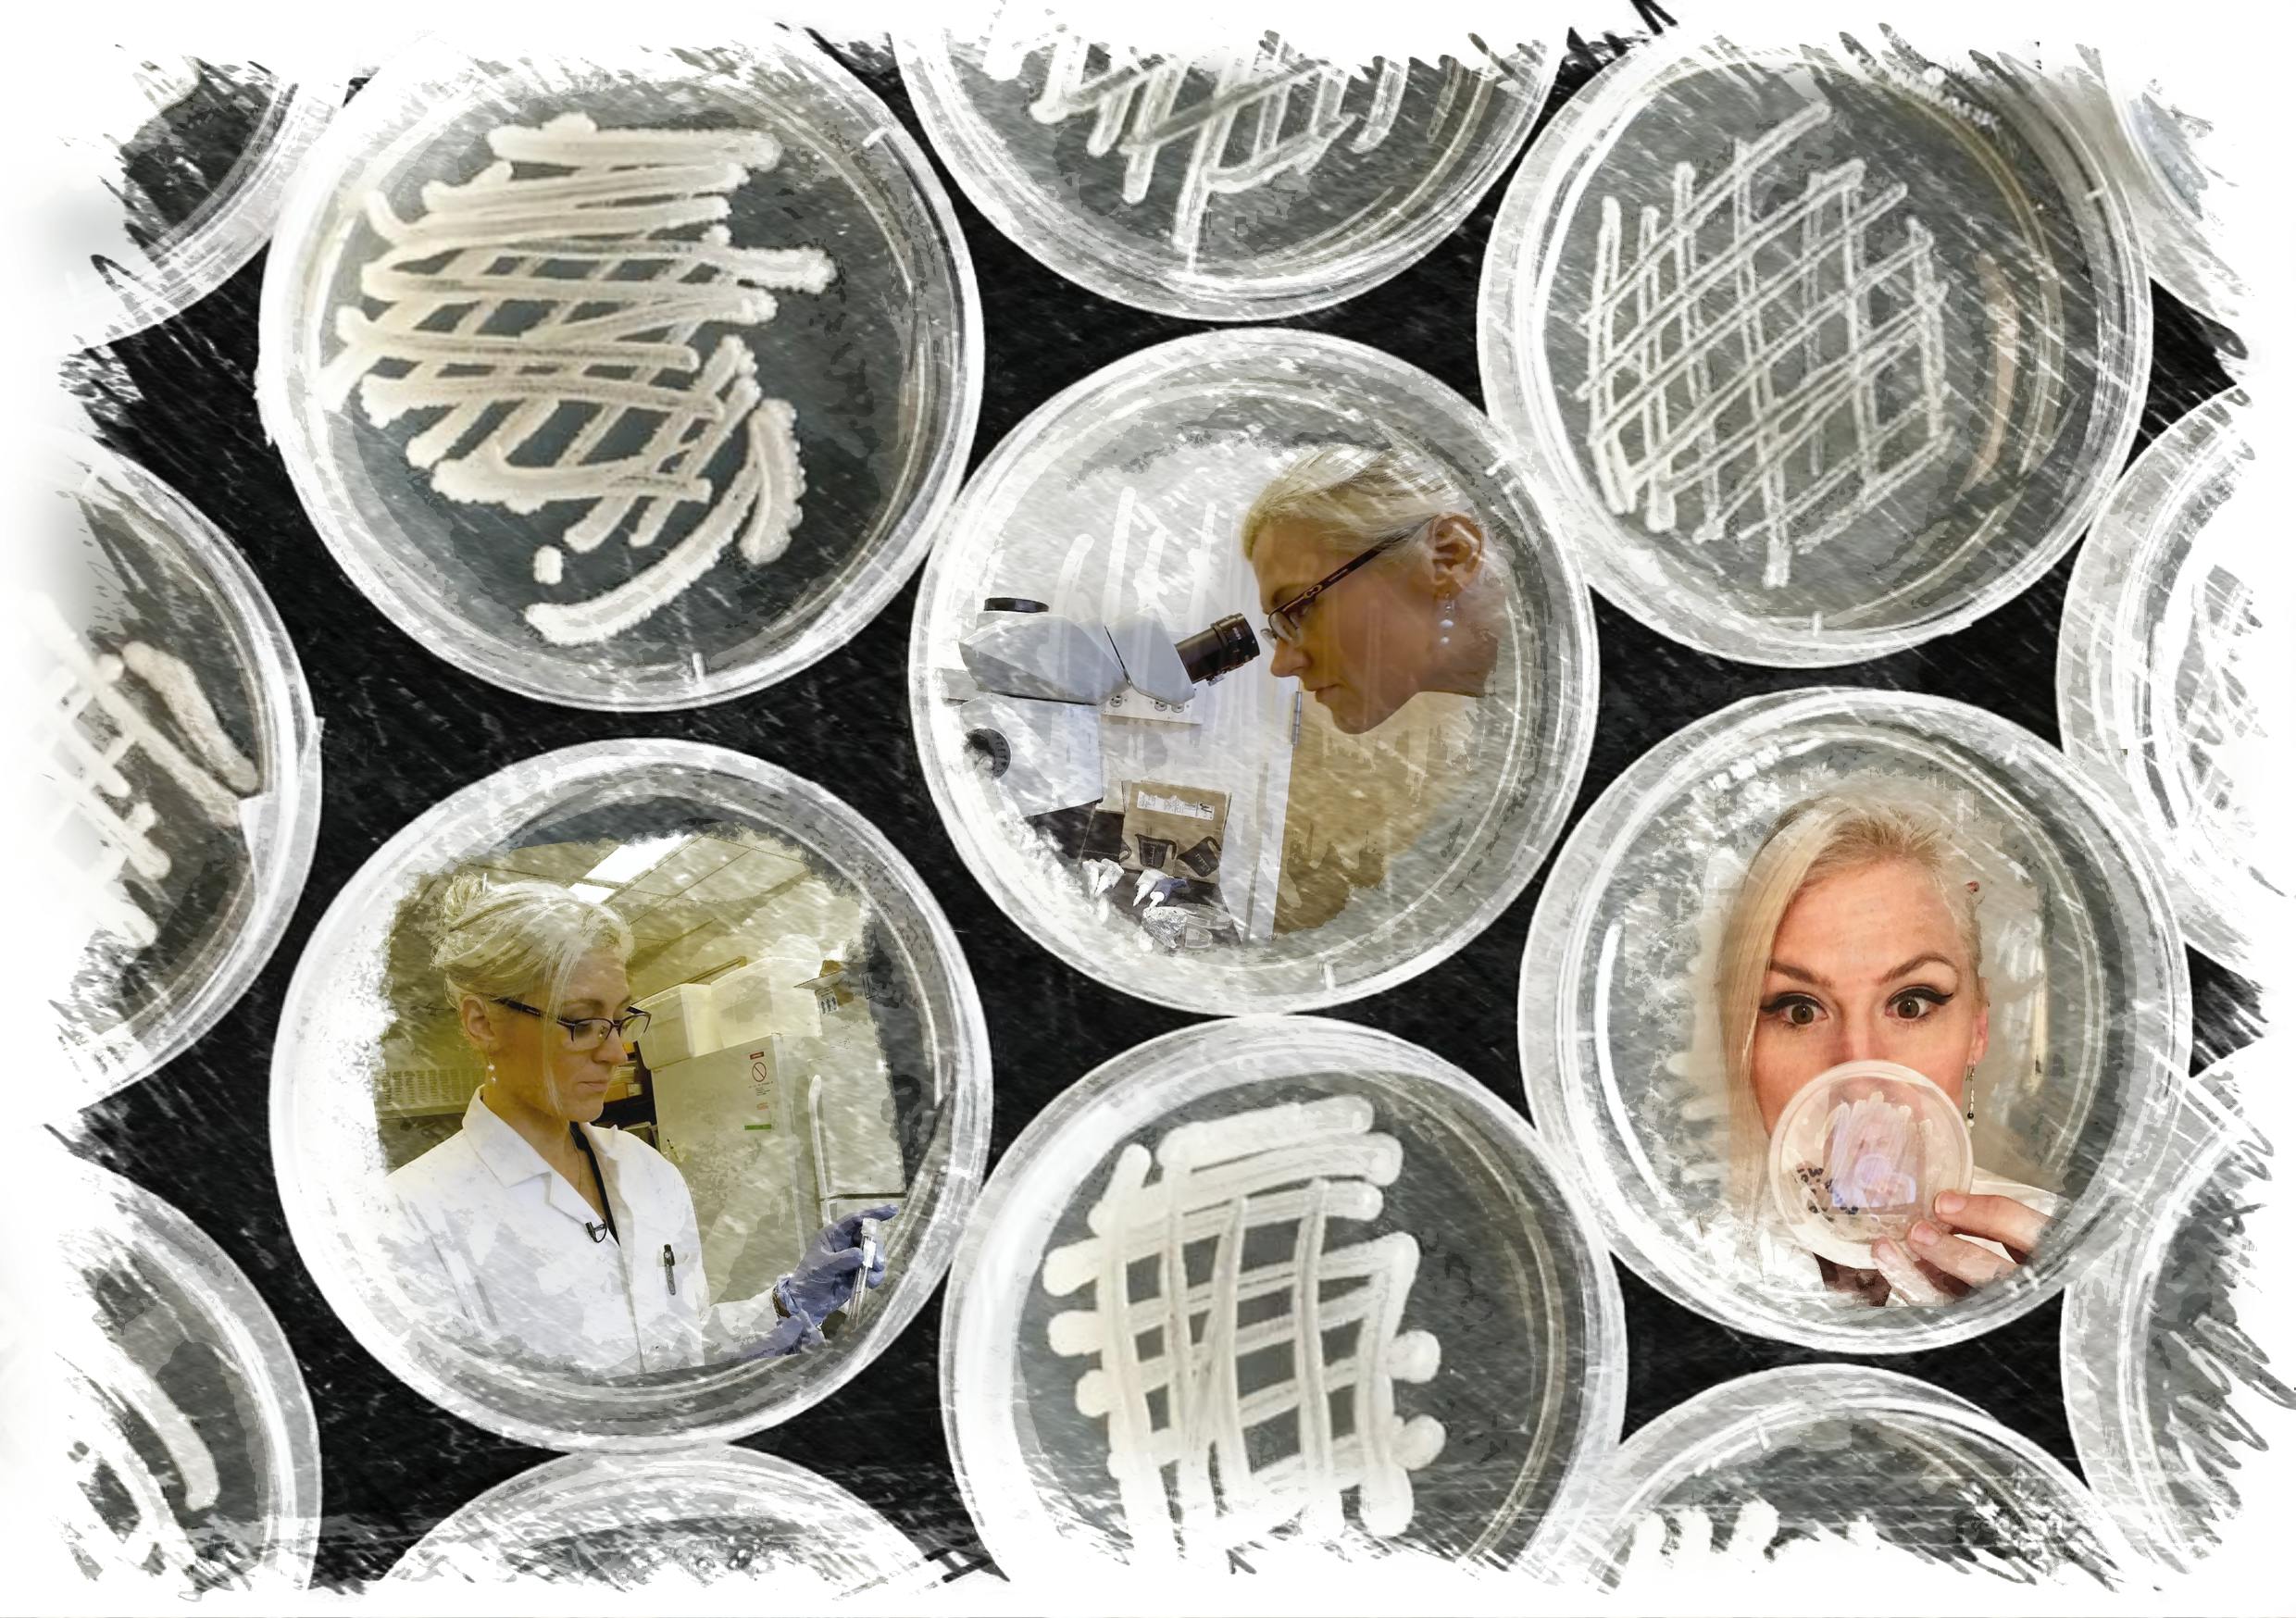

『アン』日本酒プロジェクト
マルハナバチやアシナガバチから採取する「Lachancea thermotolerans」の酵母株から作られる、世界初の日本酒。この日本酒発売プロジェクトは、アーティスト、醸造家、微生物学者の、熱心な女性3名によるコラボレーションです。
ほとんどの日本酒は、アルコールのみを作り出す最も一般的な酵母株から製造されています。
同プロジェクトのアプローチはそれらと異なり、複数の酵母による複雑な発酵手法を用いています。それによりマルハナバチやアシナガバチが作る特別な酵母から、酸味だけでなくフローラルや蜜に似た独特のアロマが生まれました。
背景:
2015年、アン・マッデン博士はマルハナバチとアシナガバチの作る酵母種にユニークな株があることを 発見しました。それは砂糖を発酵させ、アルコールと乳酸を作り出すものでした。Lachancea thermotoleransというこの新しい株は、一般的な醸造酵母の遠い親戚にあたります。
当製商品の醸造家である亀岡晶子氏が、独特のアロマと酸味を生み出すこの酵母で日本酒造りの可能性を探り始めたのは2018年のことです。分析と試験を何度も繰り返した後、彼女はこの酵母を利用することに成功しました。見事なフローラルのアロマ、そして酸味がバランスよく引き立てられた、新しいスタイルの日本酒が生まれたのです。このスタイルの日本酒が持つ酸味は白ワインのそれによく似ていますが、乳酸を含む性質のため、より控えめで柔らかな仕上がりです。わずかに深い味わいのある、生酛造りや山廃仕込みを好む方には、当商品は飲みやすく感じられるはずです。
亀岡晶子氏は、日本酒やワインの愛好家と愉しみを共有しようと新しく少量を醸造しました。
今回製造した限定版は、2本入りの新しいシリーズです。酵母を発見した科学者であるアン・マッデン博士に因み、このシリーズを名付けました。
アン・メドウにはマルハナバチの酵母が、アン・グレンにはアシナガバチの酵母が使われています。
当商品は、困難を乗り越えて生まれた他に例をみない日本酒です。この酵母で醸造された世界初の日本酒の公開、そして酵母発見を支えた科学を称えるために、特別に美しいイメージが必要でした。
【ラベルのデザインは、「ART OF ERICA WARD」エリカ・ワード氏】
限定版のアートワークを託すために亀岡晶子氏がパートナーを組んだのは、東京を拠点とする国際アーティストのエリカ・ワード氏です。
アン・メドウのラベルイメージは、花粉を集めるために牧草地(メドウ)で花から花へと忙しなく飛び回る、マルハナバチの自然の住処です。
アン・グレンのラベルには、狩りをするアシナガバチのための綺麗な水と自然に溢れた、森の渓谷(グレン)が描かれています。

絵の中央にいるのは、この素晴らしい日本酒の公開を実現するため、彼らの特別な秘密を分けてくれるようマルハナバチとアシナガバチに呼びかけているアン博士です。
エリカ・ワード氏作のこれら限定原画は、日本酒やアートファンの皆様にお買い求めいただけます。小さく優れた生き物から採取した酵母から生まれた、世界初の日本酒を祝いましょう。コラボレーションの特別ボーナスとして、原画の縁には醸造家の亀岡晶子氏によってゴールドのギルディング (金属の薄い箔を付着させる) が散りばめられています。



このプロジェクト日本酒について:
アン・メドウ / アン・グレン日本酒セット2ボトルx 500ml each
品目: 清酒
保存方法:要冷蔵(8℃以下)
品名:アン・メドウ Anne Meadow 蜂酵母のお酒
アルコール分:13度 精米歩合:60% 原材料名:米(国産)・米こうじ(国産米)
内容量:500mℓ
マルハナバチの体内から抽出された酵母で日本酒を仕込んでみました。そして協会9号酵母を加えて低温で更に発酵させ、両方の〝いいとこどり″をしたのがこの世界初のお酒です。
品名:アン・グレン Anne Glen 蜂酵母のお酒
アルコール分:15度 精米歩合:60% 原材料名:米(国産)・米こうじ(国産米)
内容量:500mℓ
アシナガバチの体内から抽出された酵母で日本酒を仕込んでみました。そして愛媛酵母EK-7を加えて低温で更に発酵させ、両方の〝いいとこどり″をしたのがこの世界初のお酒です。
白い花々、カモミール、マスカット、メロン、ジャックフルーツ、アプリコット、バナナ、その他多数のアロマを感じられるかもしれません。
最後に、当製品の公開は、女性たちによる現代世界への貢献、そして新しく困難なことへ挑戦した当チームのコラボレーションを称えるものです。
当商品をお飲みになる方へ:
ワイングラスやチューリップ型の日本酒杯のような、香りがよく分かるグラスで愉しまれることをお勧めします。酸味を好まれる方なら、リーデルの日本酒用純米グラスのように幅広のボウル状グラスをご利用ください。
熱燗でも美味しくいただけますので、是非試してみてください。肌寒い日が増えてきたこの時期に楽しみたい熱燗には、木本硝子株式会社樣によるフラスコとビーカーの形のユニークな耐熱ガラスでお試し下さい。
ペアリング:
アンは、乾燥肉、ムース、リエット、チーズ、フルーツ、ナッツが乗ったどんなシャキュテリープレートとも美味しく組み合わせることができます。ゴルゴンゾーラやロクフォートのように、より深みのある濃厚なブルーチーズがこの種の日本酒には相性抜群です。パルミジャーノ・レッジャーノのような熟成されたハードチーズもよく合います。
そういった種類のチーズはタンパク質と脂質のバランスが良く、塩味も伴っています。そのため、当製品との相性の良さが引き立ちます。たっぷりのチーズや強い風味のチーズを使ったピザ、パスタ料理も合わせてみましょう。蜂蜜なしで美味しくいただけます。
カスタードやクリーム、数種類の果物とも合います。カスタードのタルト、クレームブリュレは常に良い選択肢です。メロンの冷製スープも理想的ですし、桃やネクタリンなどの核果もよく合います。
その他の可能性:
伝統的な東南アジアのカレーや、昔ながらのピリッとしたアメリカン・バーベキューといったスパイスの効いたお料理とどうぞ。 ローストビーフや焼き鳥などとも良く合います。
公開にあたって:当製品は、酵母の増殖から材料の発酵、慎重なハンドプレスによるろ過作業、ボトル詰めや梱包に至るまで、亀岡晶子氏が全てを手がけました。その成果にご満足いただけることを願っています。

試飲コンセプトテストレビュー

醸造家のメッセージ:
蜂の体内から抽出された酵母を使った日本酒は、米が原料とは思えないフルーティーさと甘酸っぱい味わいが特徴です。酸の高い日本酒は他にもありますが、この酵母の酸味と米麹由来の甘みは、今まで味わった事のない得も言われぬものになりました!アプリコットやバナナを連想させる芳醇な香りもまたユニーク。百聞は一見(一味)にしかず、この機会に是非ご賞味ください。
亀岡晶子氏について:
日本大学理工学部卒業後、イギリスの大学で野生動物の保護について学び帰国。 その後、野生動植物の保護団体WWFで働いた後、2003年実家のある愛媛に帰郷し、実家の酒蔵を手伝い始めた。その後、蜂酵母のユニークさに魅せられ、それで世界初の日本酒を醸造。

エリカ・ワード氏について:
Erica Ward is a California-native artist living in Tokyo. Her detailed Japan-inspired works of watercolor and ink combine the mundane and the surreal.
カリフォルニア生まれ東京在住の水彩画アーティスト。幼いころから絵を描くのが好きなワードは14才で初めて日本を訪問し、大きな影響を受ける。2009年マサチューセッツ大学日本語学部を卒業し、再びインスピレーションの源となる日本に戻る。2013年、岩手県で日本での初個展を開催。10年間で東北、関西、関東を渡り住み、日本で経験したものごとが作品に映り込む。浮世絵やアールヌーヴォーにインスパイアされたスタイルで、ペンのはっきりした輪郭と水彩の優しい色で美人画を描く。2016年からは拠点を東京に移し、高層ビル、路線など大都会の風景が作品に現れ始める。


アン・マッデン博士について:
アン・A・マッデンPh.D. 科学者、発明家、科学のコミュニケーター。
アン・A・マッデン博士(バイオグラフィー)は、分野をまたいで活躍する博学者です。彼女は微生物学者であり、発明家であり、起業家であり、そして科学のコミュニケーターです。受賞歴を持つ科学者として、彼女は業界全般にわたり微生物の発見経路を構築してきました。そして世界的に有名な講演者でもあります。マッデン博士は、食品飲料技術企業であるLachancea LLCの技術共同設立者兼最高科学責任者です。また、ノースカロライナ州立大学の応用生態学学部で非常勤准教授を務めています。科学コミュニケーション、革新的な製品開発、戦略的提携について、彼女は様々な規模の企業にコンサルティングを提供しています。そのグループには小さな会社からフォーチュン500企業、MITのような大学まであらゆる機関が含まれています。

当プロジェクトは、日本酒専門家のチャールズ・スチュワート氏の発想からデザインされ、コーディネートされたものです。スチュワート氏は日本で酵母株を販売しています。
(Lachancea thermotolerans ・ハチ酵母について)









『アン』日本酒プロジェクトリリースパーティーRelease Party Reservation 2020年2月11日 (火) 科学における女性と女児の国際デー https://lachancea.peatix.com/